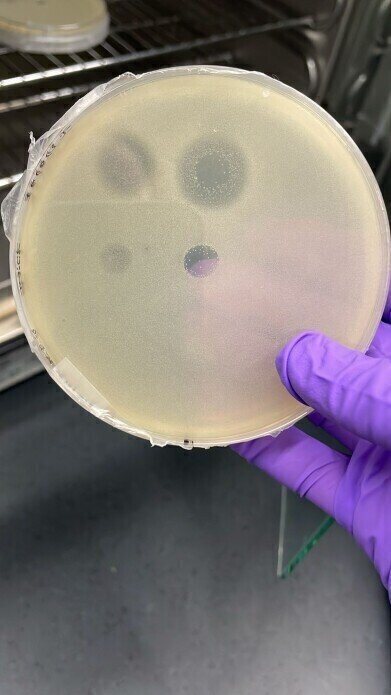

-
 The salt-loving Halalkalibacterium halodurans, growing on a petri dish in the Warnecke lab, is killed by proteins secreted by the archaeon Halogranum salarium. Credit: Aida Sanchez-Ricol (Warnecke lab) (CC-BY 4.0, https://creativecommons.org/licenses/by/4.0/)
The salt-loving Halalkalibacterium halodurans, growing on a petri dish in the Warnecke lab, is killed by proteins secreted by the archaeon Halogranum salarium. Credit: Aida Sanchez-Ricol (Warnecke lab) (CC-BY 4.0, https://creativecommons.org/licenses/by/4.0/) -
Research news
Little known archaea found to produce potent antibacterials
Aug 14 2025
Archaea – a major domain of single-celled microorganisms which is distinct from bacteria and eukaryotes – has been found to produce potent antibacterial proteins, according to research that has highlighted their potential as a reservoir for novel antimicrobials. The study undertaken by researchers from the University of Oxford and the UK’s Medical Research Council Laboratory of Medical Sciences, has provided the first insight into the molecular defences of archaea and underscored the value of surveying diverse microbes to identify previously unknown chemical weapons against antimicrobial resistance.
Microorganisms compete for space and resources by producing molecules to inhibit or destroy rivals. While all existing antibiotics originated from such systems, investigations have focused almost exclusively on bacteria and fungi. Archaea, which number more than 20,000 known species, frequently live among dense bacterial populations and are therefore likely to require mechanisms by which to compete and survive.
The researchers analysed the genomes of more than 3,700 archaeal species to identify genes encoding proteins capable of degrading peptidoglycan – a key structural component of bacterial cell walls that archaea themselves do not possess. Such proteins were found in about 5% of the species examined, with some harbouring several distinct types.
Laboratory tests demonstrated that these proteins could kill bacteria, and structural studies suggested that many were secreted from the archaeal cell. Some species also carried genes for components of injection systems that might directly deliver these proteins into competing bacteria.
AI identifies potential antibiotic effects in ancient microbes called Archaea
A type of microbe that can inhabit extreme environments such as hydrothermal vents may produce compounds that science can use to combat drug-resistant bacteria, according to research that has appli... Read More
Much remains to be discovered about the role of these molecular weapons in natural environments. The peptidoglycan-degrading proteins represent only one category of antibacterial agents that may be present among archaea.
“Archaea are their own Domain of Life, different from bacteria, and different from eukaryotes,” said Tobias Warnecke, senior author of the study.
“We know very little about their social lives, including how they interact with their ubiquitous brethren – bacteria.
“Our work sheds light on these interactions and suggests that archaea might be a large, untapped reservoir for discovering novel antimicrobials,” he concluded.
First author Romain Strock added: “Archaea are often depicted as either lone extremophiles or syntrophic partners.
“Our research reveals another, darker side to their social life.”
Archaea share a superficially similar cell structure with bacteria but differ in genetic composition, evolutionary history, and membrane chemistry. They inhabit environments ranging from extreme heat, salinity, and acidity to more temperate habitats, including soils, oceans, and the human gut.
Many are methanogens, producing methane as a metabolic by-product, and none are known to cause disease in humans or animals. Their enzymes are valued in biotechnology for their stability under extreme conditions, and they play essential roles in global nutrient cycling.
For further reading please visit: 10.1371/journal.pbio.3003235
Digital Edition
Lab Asia Dec 2025
December 2025
Chromatography Articles- Cutting-edge sample preparation tools help laboratories to stay ahead of the curveMass Spectrometry & Spectroscopy Articles- Unlocking the complexity of metabolomics: Pushi...
View all digital editions
Events
Jan 21 2026 Tokyo, Japan
Jan 28 2026 Tokyo, Japan
Jan 29 2026 New Delhi, India
Feb 07 2026 Boston, MA, USA
Asia Pharma Expo/Asia Lab Expo
Feb 12 2026 Dhaka, Bangladesh



















